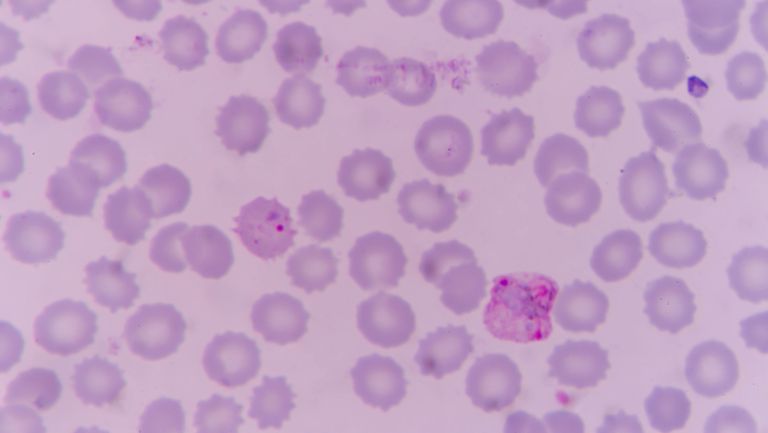

Appreciating health workers in the COVID fight isn’t ‘nice’: it’s a moral duty
Darren Menachemmson discusses our moral duties to frontline COVID-19 health workers

How can you meaningfully engage with your participants in a virtual workshop?
One of the major benefits of a face to face workshop is that it is engaging for people.


Helping you drive change towards vibrant communities, strong economies, sustainable environments and trusted institutions.
What do you want to change today? Let's talk


We have adopted the United Nations Sustainable Development Goals as our guiding principles